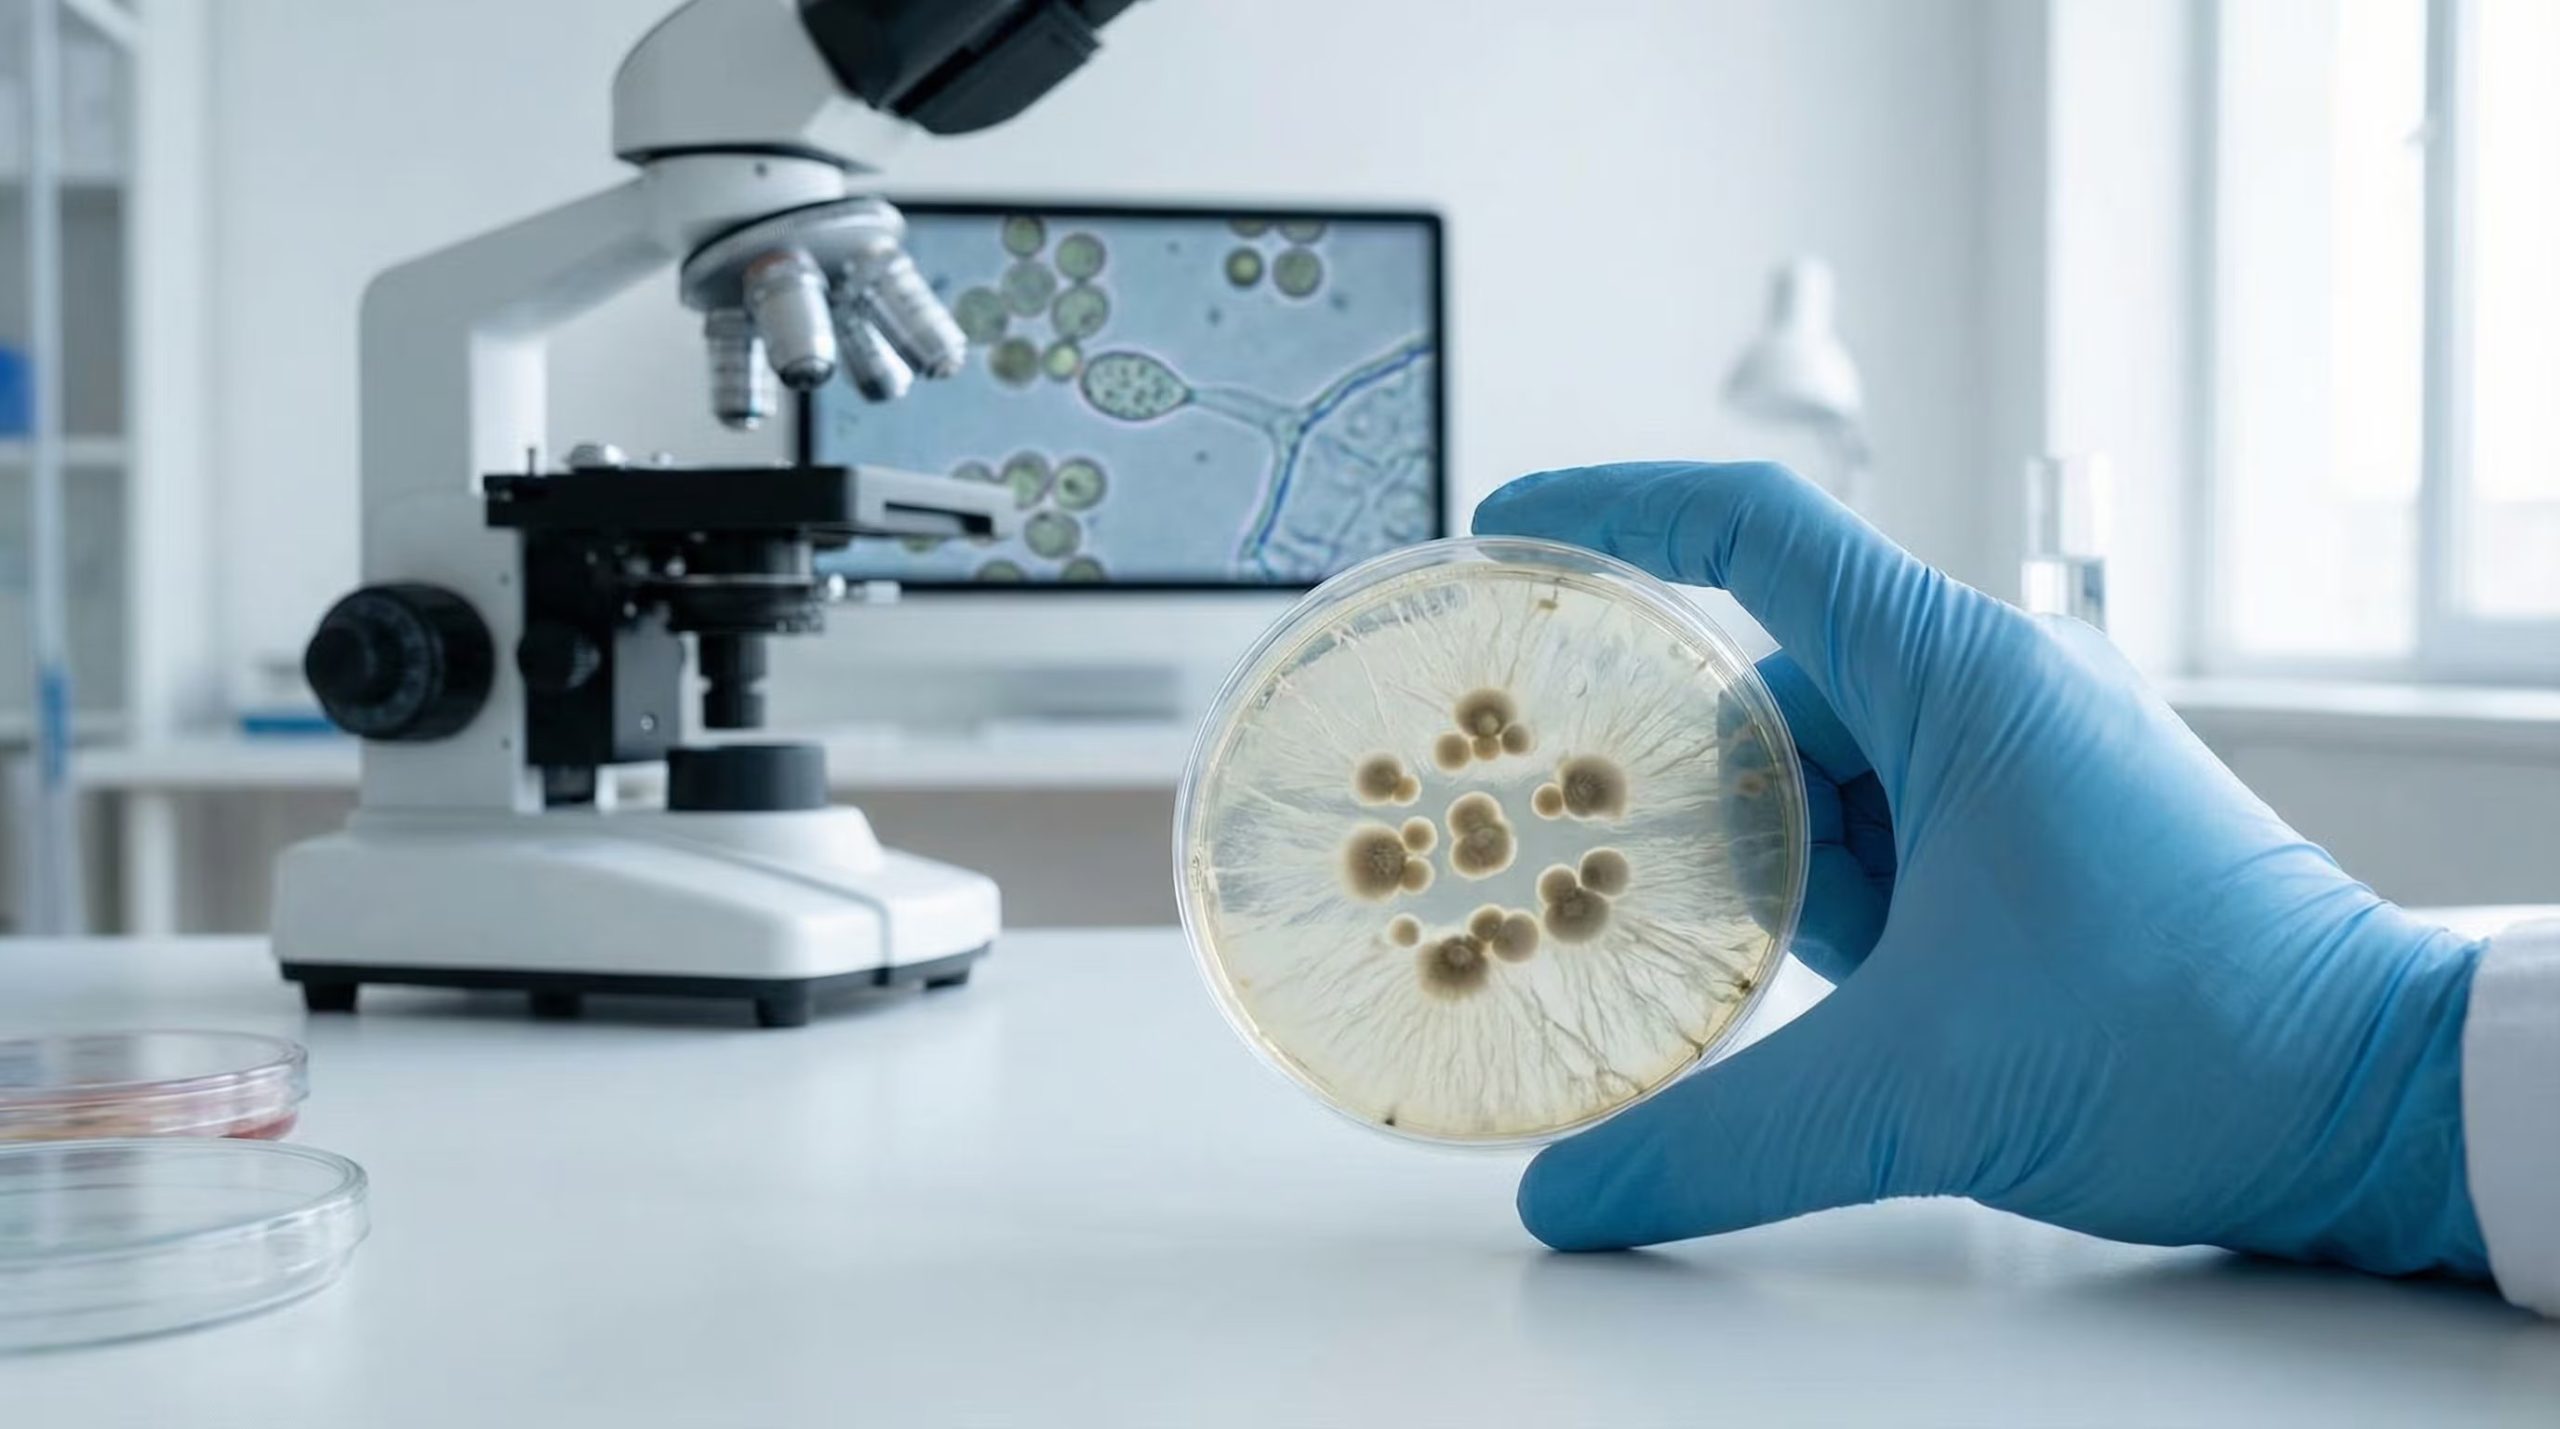
El experimento detalla que los microorganismos soportan presiones implicadas en trayectos espaciales que podrían conectar la superficie de Marte con Fobos y Deimos (Imagen Ilustrativa Infobae)

La asombrosa capacidad de supervivencia de ciertas bacterias frente a entornos hostiles ha provocado que la comunidad científica revalúe las teorías sobre el comienzo de la vida en la Tierra y las estrategias para proteger otros mundos durante las exploraciones espaciales. Un reciente análisis llevado a cabo por investigadores de la Universidad Johns Hopkins ha comprobado que diversos microorganismos tienen la facultad de resistir presiones mecánicas de enorme intensidad, comparables a las que ocurren durante las colisiones de grandes asteroides. Este hallazgo fortalece la hipótesis de que ciertas formas biológicas podrían trasladarse de un cuerpo celeste a otro a través de fragmentos de roca espaciales.
La investigación, que fue difundida a través de la revista científica PNAS Nexus, contó con el liderazgo de KT Ramesh. El equipo de trabajo estructuró un ensayo para determinar si una bacteria de tipo extremófilo podía tolerar la fuerza generada por el impacto y la posterior expulsión de escombros desde la superficie de Marte, un proceso natural que ha permitido que meteoritos marcianos lleguen eventualmente a nuestro planeta. Este estudio se centra específicamente en la litopanspermia, teoría que sugiere que la vida es capaz de propagarse por el cosmos viajando en rocas lanzadas por choques cósmicos.
El núcleo de la interrogante científica era determinar si los organismos vivos pueden salir airosos de los violentos impactos mecánicos y del vacío espacial para finalmente colonizar nuevos mundos. Previo a este trabajo, la mayoría de los experimentos se habían centrado en bacterias comunes de nuestro entorno y no en especímenes con adaptaciones extremas que pudieran asemejarse a las condiciones hipotéticas de Marte.
Para profundizar en este campo, los expertos seleccionaron a la bacteria Deinococcus radiodurans. Este microorganismo, que habita en las zonas áridas del norte de Chile, es célebre por su inmunidad ante el frío extremo, la deshidratación y la radiación letal. Fisiológicamente, posee una estructura exterior robusta y una eficiencia única para reconstruir su propio ADN. Según las declaraciones que KT Ramesh ofreció a PNAS Nexus,
“aún no sabemos si hay vida en Marte, pero si la hay, es probable que tenga capacidades similares”
a las que presenta la Deinococcus radiodurans.
Resistencia ante presiones masivas
El procedimiento experimental consistió en colocar muestras de la bacteria en medio de dos placas de acero, las cuales fueron sometidas al impacto de un proyectil lanzado a una velocidad de 480 km/h mediante el uso de una pistola de gas. Dicho impacto produjo presiones situadas entre 1 y 3 gigapascales (GPa). Para poner estos datos en perspectiva, estas cifras superan cualquier fenómeno de presión natural en nuestro planeta: incluso el fondo de la Fosa de las Marianas, el sitio más profundo de los océanos terrestres, registra apenas una décima parte de un GPa.

Tras las colisiones, se procedió a evaluar la vitalidad de los microorganismos y a rastrear posibles alteraciones genéticas para comprender cómo logran sobrevivir. Los hallazgos superaron las previsiones iniciales: la Deinococcus radiodurans logró sobrevivir a la totalidad de las pruebas de 1,4 GPa y mantuvo un índice de supervivencia del 60% incluso a 2,4 GPa. Aunque a niveles de presión más elevados se detectaron daños en las membranas y estructuras internas, gran parte de la población bacteriana resistió los impactos de menor intensidad sin problemas visibles.
Lily Zhao, quien figura como autora principal del estudio, comentó sobre la sorprendente dureza del espécimen:
“Esperábamos que estuviera muerto con esa primera presión. Empezamos a dispararle cada vez más rápido. Seguimos intentando matarlo, pero era realmente difícil”
. La resistencia fue tal que incluso el sistema de soporte de las placas metálicas falló antes que las propias bacterias.
Se estima que los restos de roca lanzados desde Marte pueden experimentar presiones de hasta 5 GPa, aunque no todo el material sufre el mismo nivel de estrés. Con estos nuevos registros, se confirma que la bacteria puede sobrevivir en rangos cercanos a los 3 GPa, superando con creces las estimaciones de estudios previos sobre la resiliencia biológica.
Consecuencias para la exploración espacial
Este descubrimiento tiene un impacto directo en los protocolos de protección planetaria de las organizaciones espaciales. Actualmente, las misiones a otros planetas deben seguir normas rigurosas de descontaminación para no llevar vida terrestre a otros mundos y para evitar que organismos externos lleguen a la Tierra en muestras recolectadas.
Sobre esto, Lily Zhao enfatizó:
“hemos demostrado que es posible que la vida sobreviva a un impacto y una eyección a gran escala. Eso significa que la vida podría potencialmente desplazarse entre planetas. ¡Quizás seamos marcianos!”

Los investigadores señalaron que los materiales eyectados de Marte podrían alcanzar fácilmente satélites cercanos como Fobos y Deimos, donde las presiones de llegada serían mucho menores que las necesarias para arribar a la Tierra. En este sentido, Fobos se presenta como un lugar sumamente susceptible de albergar microorganismos supervivientes debido a estas bajas presiones de impacto. Ante este panorama, Ramesh advirtió que
“tendremos que ser muy cuidadosos con los planetas que visitamos”
.
En el futuro, el equipo tiene el objetivo de analizar si los impactos constantes permiten que las bacterias generen descendencia con una resistencia aún mayor. Asimismo, plantean extender las pruebas a otros reinos, como los hongos, para verificar si esta invulnerabilidad es una característica compartida por otros organismos. El proyecto contó con la participación fundamental de César A. Pérez-Fernández y Jocelyne DiRuggiero, quienes aportaron su experiencia en biología adaptativa en entornos extremos.
Como conclusión, los académicos de la Universidad Johns Hopkins sostienen que las evidencias obligan a replantear el modelo de la panspermia, sugiriendo que la vida más resistente posee una capacidad migratoria y de adaptación mucho más potente de lo que la ciencia había imaginado hasta ahora.
Fuente: Fuente